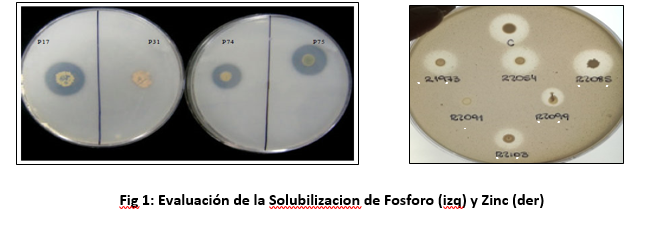
Blog Images

Copyright © 2022 Power Bales. Todos los derechos reservados.
MicroBioTecnologías de BioFertilización y Bioestimulación Nutricional y Metabólica
MicroBioTecnologías de BioFertilización y Bioestimulación Nutricional y Metabólica
Los cultivos, tanto seres vivos, necesitan nutrirse y estimular su fisiología y metabolismo; a los efectos de poder incrementar su crecimiento, desarrollo y la producción de biomasa y/o el rendimiento en granos; para lo cual la interacción microorganismo-planta aporta significativamente a la nutrición y la funcionalidad vegetal.
Dentro del inmenso mundo microbiano existen numerosas funciones que mejoran la performance de los cultivos y además coadyuvan a reducir deficiencias múltiples como la provisión de nutrientes y la mitigación de estreses abióticos; como el déficit hídrico y térmico que impactan sobre el normal crecimiento y desarrollo de las plantas.
Esta multiplicidad funcional microbiana ha permitido desarrollar numerosas herramientas microbiológicas; que por un lado permiten fijar biológicamente un nutriente esencial para la construcción de estructura vegetal como es el nitrógeno; que es cubierto a través del proceso de la simbiosis leguminosas-rizobios; tanto en los cultivos de soja y otras leguminosas de granos. Además, el aporte de la Fijación Biológica del Nitrógeno (FBN) a la producción de biomasa en cultivos forrajeros (alfalfa, tréboles, etc) y cultivos de servicios (vicia) es realmente considerable y cubre un alto porcentaje de los requerimientos de Nitrógeno.
Prueba de ello son los trabajos realizados bajo condiciones de campo efectuados en distintos ambientes AgroEdafoClimáticos del país. En este sentido el trabajo realizado por Perticari y colaboradores es una muestra concreta del impacto de la MicrobioTecnología de Biofertilización que contempla prácticamente la totalidad de los ciclos agrícolas de este siglo:

Al mismo tiempo diferentes investigadores han demostrado; en numerosos experimentos la capacidad de incrementar los rendimientos en grano y/o en producción de materia seca sobre todo en el caso de cultivos forrajeros como la alfalfa; en donde se observa el impacto de la FBN en diferentes sitios experimentales:

Claramente, entonces, las tecnologías microbiológicas de inoculación realizan un aporte significativo a los rendimientos; al ambiente y a la ecuación económica de la producción de diferentes leguminosas y en especial del cultivo de soja; pero además en los últimos años se han mejorado de manera sustantiva las formulaciones que aseguran una serie de beneficios con los que se obtienen mayores impactos productivos; entre ellos podemos mencionar:
- Alta concentración microbiana por ml de inoculante ( +10 10 bacterias por mililitro);
- Alta supervivencia de los microorganismos en los envases contenedores (18 meses a varios años si se mantienen en condiciones de temperaturas moderadas);
- Alta supervivencia y compatibilidad con diferentes fungicidas e insecticidas; cuando estos productos son aplicados sobre las semillas y
- Alta compatibilidad con otros microorganismos de uso cada vez más frecuente en los tratamientos de semilla o de aplicaciones en el surco (Trichoderma, Bacilus, Azospirillum, etc).
Todas estas mejoras en las MicroBioFormulaciones aseguran mejor nodulación, mayor peso seco nodular y especialmente mejor actividad de la enzima nitrogenasa; que es la que cataliza la transformación de un recurso prácticamente inagotable de la atmosfera; como lo es el gas N2, que se encuentra en una concentración en el aire del 79%; en Amonio.
Complementariamente; esta función y capacidad de FBN no se agota en la Fijación Simbiótica del Nitrógeno de las bacterias con las leguminosas; sino que también son de gran importancia las estrategias de inoculación que vehiculizan a través de la semilla distintos microorganismos como Azospirillum, Herbaspiribum, entre otros; que permiten en asociación con los cultivos no leguminosas aportar nitrógeno a través de la FBN complementando así el nitrógeno como nitrato absorbido a través de los procesos también microbianos de nitrificación; aumentando de esta forma la oferta total del nutriente a los cultivos y muy especialmente a distintos tipos de gramíneas como los cultivos de cereales de invierno y los cultivos de maíz y sorgo. Cuadro 1 Impacto de la FBN y otras capacidades PGPR en No leguminosas (Maíz).

Cuadro 1 Impacto de la FBN y otras capacidades PGPR en No leguminosas (Maíz) a diferentes niveles de fertilización (Control: Testigo y Inoculated: Tratamiento con Azospirillum brasilense) (316 sitios experimentales). Diaz Zorita et al, 2015
Adicionalmente, no podemos dejar de mencionar una nueva revolución nutricional que está en sus comienzos a nivel de lotes de producción extensivos; que es la nutrición nitrogenada a través de la inoculación foliar de microorganismos.
Estas Herramientas Microbiológicas: Biofertilizantes de Nitrógeno; se encuentran representados por diferentes microorganismos de los géneros: Metilobacterium, Burkolderia Gluconoacetobacter, etc.
Al utilizar este tipo de tecnologías es fundamental ser muy cuidadosos en la preservación de la supervivencia microbiana sobre la superficie foliar; para que después se produzca el ingreso microbiano al interior vegetal y lleve adelante el aporte deseado. Es clave entonces en el caso de estas MicrobioTecnologías Foliares la calidad y el momento en el que se realicen las aplicaciones. Cuando estas precauciones son tenidas en cuenta los impactos productivos son interesantes como los que se observan en distintos trabajos de campo. Grafico 1 Impacto de la Biofertilización Foliar Microbiana.

Grafico 1 Impacto de la Biofertilización Foliar Microbiana (Barra Blanca Testigo sin inocular; Barra Gris Met (Metilobacterium sp) Torres Vera et al 2023
Otro de los aportes significativos que logramos con el uso de MicroBiotecnologías es el relacionado con la Bioestimulación y la Biodisponibilidad de nutrientes para los cultivos. En esta temática en particular han sido determinadas una serie de funciones que los microorganismos aportan a los cultivos y que fundamentalmente podemos agrupar de la siguiente forma:
I.Solubilización de Nutrientes: Fosforo, Zinc, Azufre, Potasio. La generación por parte de distintos microorganismos de ácidos orgánicos y múltiples enzimas permite biodisponer nutrientes a la solución del suelo; favoreciendo una mayor y mejor nutrición vegetal. (Figura 1 Evaluación de la Solubilización de Fosforo (izq) y Zinc (der):
II.Actividad Hormonal: Acido Indol Acético. La producción microbiana de fitohormonas como las auxinas incrementa la división celular y permite la generación de mayor bifurcación de pelos radiculares que implican una mayor exploración del suelo y con ella una mejor captura de agua y nutrientes. (Figura 2 Evaluación de la Actividad Indol Acética).

III.Actividad Nitrato Reductasa: La transformación de nitratos a amonio; es un proceso que los microorganismos llevan adelante y que es clave para que posteriormente los cultivos generen proteínas usadas en la construcción de estructura celular y actividad metabólica. Esta capacidad microbiana Nitrato Reductasa; además de aportar a la transformación del nitrógeno; aumenta la retención del nitrógeno en suelo; ya que el amonio puede ser retenido por los coloides del suelo a diferencia del nitrato que posee una gran movilidad y tiende a lixiviarse o percollar a las capas inferiores de los suelos y acumularse en la napa freática con los inconvenientes que esto produce desde la perspectiva ambiental. Fig 3: Evaluación Cuali-Cuantitativa de la Actividad Nitrato Reductasa.

IV.Actividad ACC De Aminasa. Esta capacidad microbiana; tal vez una de las funciones menos conocidas de la Microflora; es sin embargo, de gran utilidad; ya que esta enzima microbiana es capaz de regular el metabolismo del etileno; produciendo una reducción significativa de esta molécula; y de esta forma las plantas pueden extender su periodo vital; con lo cual se incrementan las posibilidades de acumulación de materia seca y con ello de impactar positivamente sobre el crecimiento, desarrollo y rendimiento de los cultivos. Fig 4.Evaluacion de las capacidades ACC De aminasa de distintos microorganismos.

La utilización y manejo de esta multiplicidad de funciones microbianas permiten promover diferentes aspectos de la bioestimulación, bionutrición, biomodulación y biomitigación que impactan positivamente en la producción de distintos cultivos.
La utilización y manejo de esta multiplicidad de funciones microbianas permiten promover diferentes aspectos de la bioestimulación, bionutrición, biomodulación y biomitigación que impactan positivamente en la producción de distintos cultivos.

Grafico 2 Impacto Productivo de la utilización de Microorganismos Bioestimuladores PGPR (Pseudomonas flourecens) en el cultivo de trigo. Gonzalez Anta et al 2021.
Finalmente es importante comentar que hoy contamos con herramientas microbianas que podemos emplear en asociaciones de consorcios microbianos con diferentes fertilizantes; particularmente microorganismos bacterianos del grupo de las Gram Positivas; capaces de generar endosporas que sobreviven a la reacción acida y salina de los fertilizantes inorgánicos y orgánico mineral e impactan significativamente en la producción de biomasa y/o rendimiento de diferentes cultivos y mejoran el uso y performance de los fertilizantes. Grafico 3: Impacto del empleo de Consorcios Microbianos (Endosporas) sobre el rendimiento en grano de cultivos de trigo. Control Fertilizado. C.Microbiano (Fertilizante + Consorcio Microbiano)

Grafico 3: Impacto del empleo de Consorcios Microbianos (Endosporas) sobre le rendimiento en grano de cultivos de trigo. Control Fertilizado. C.Microbiano (Fertilizante + Consorcio Microbiano) González Anta et al 2023.
El empleo de MicroBioTecnologías de Biofertilización y Bioestimulación han y están demostrando impactos productivos sustanciales dentro de los planteos de producción agrícola.
Este uso creciente de MicrobioTecnologías está perfectamente alineado con el nuevo paradigma agronómico que prioriza la producción en cantidad y calidad de granos y biomasa; pero al mismo tiempo propone obtener estos objetivos dentro de un marco de referencia donde se reduzca de manera significativa el impacto ambiental y se mitiguen los efectos del cambio climático y los estreses fundamentalmente abióticos; cada vez más frecuentes en nuestros ambientes productivos.
Por: Gustavo González Anta
Fuente: Horizonte A

